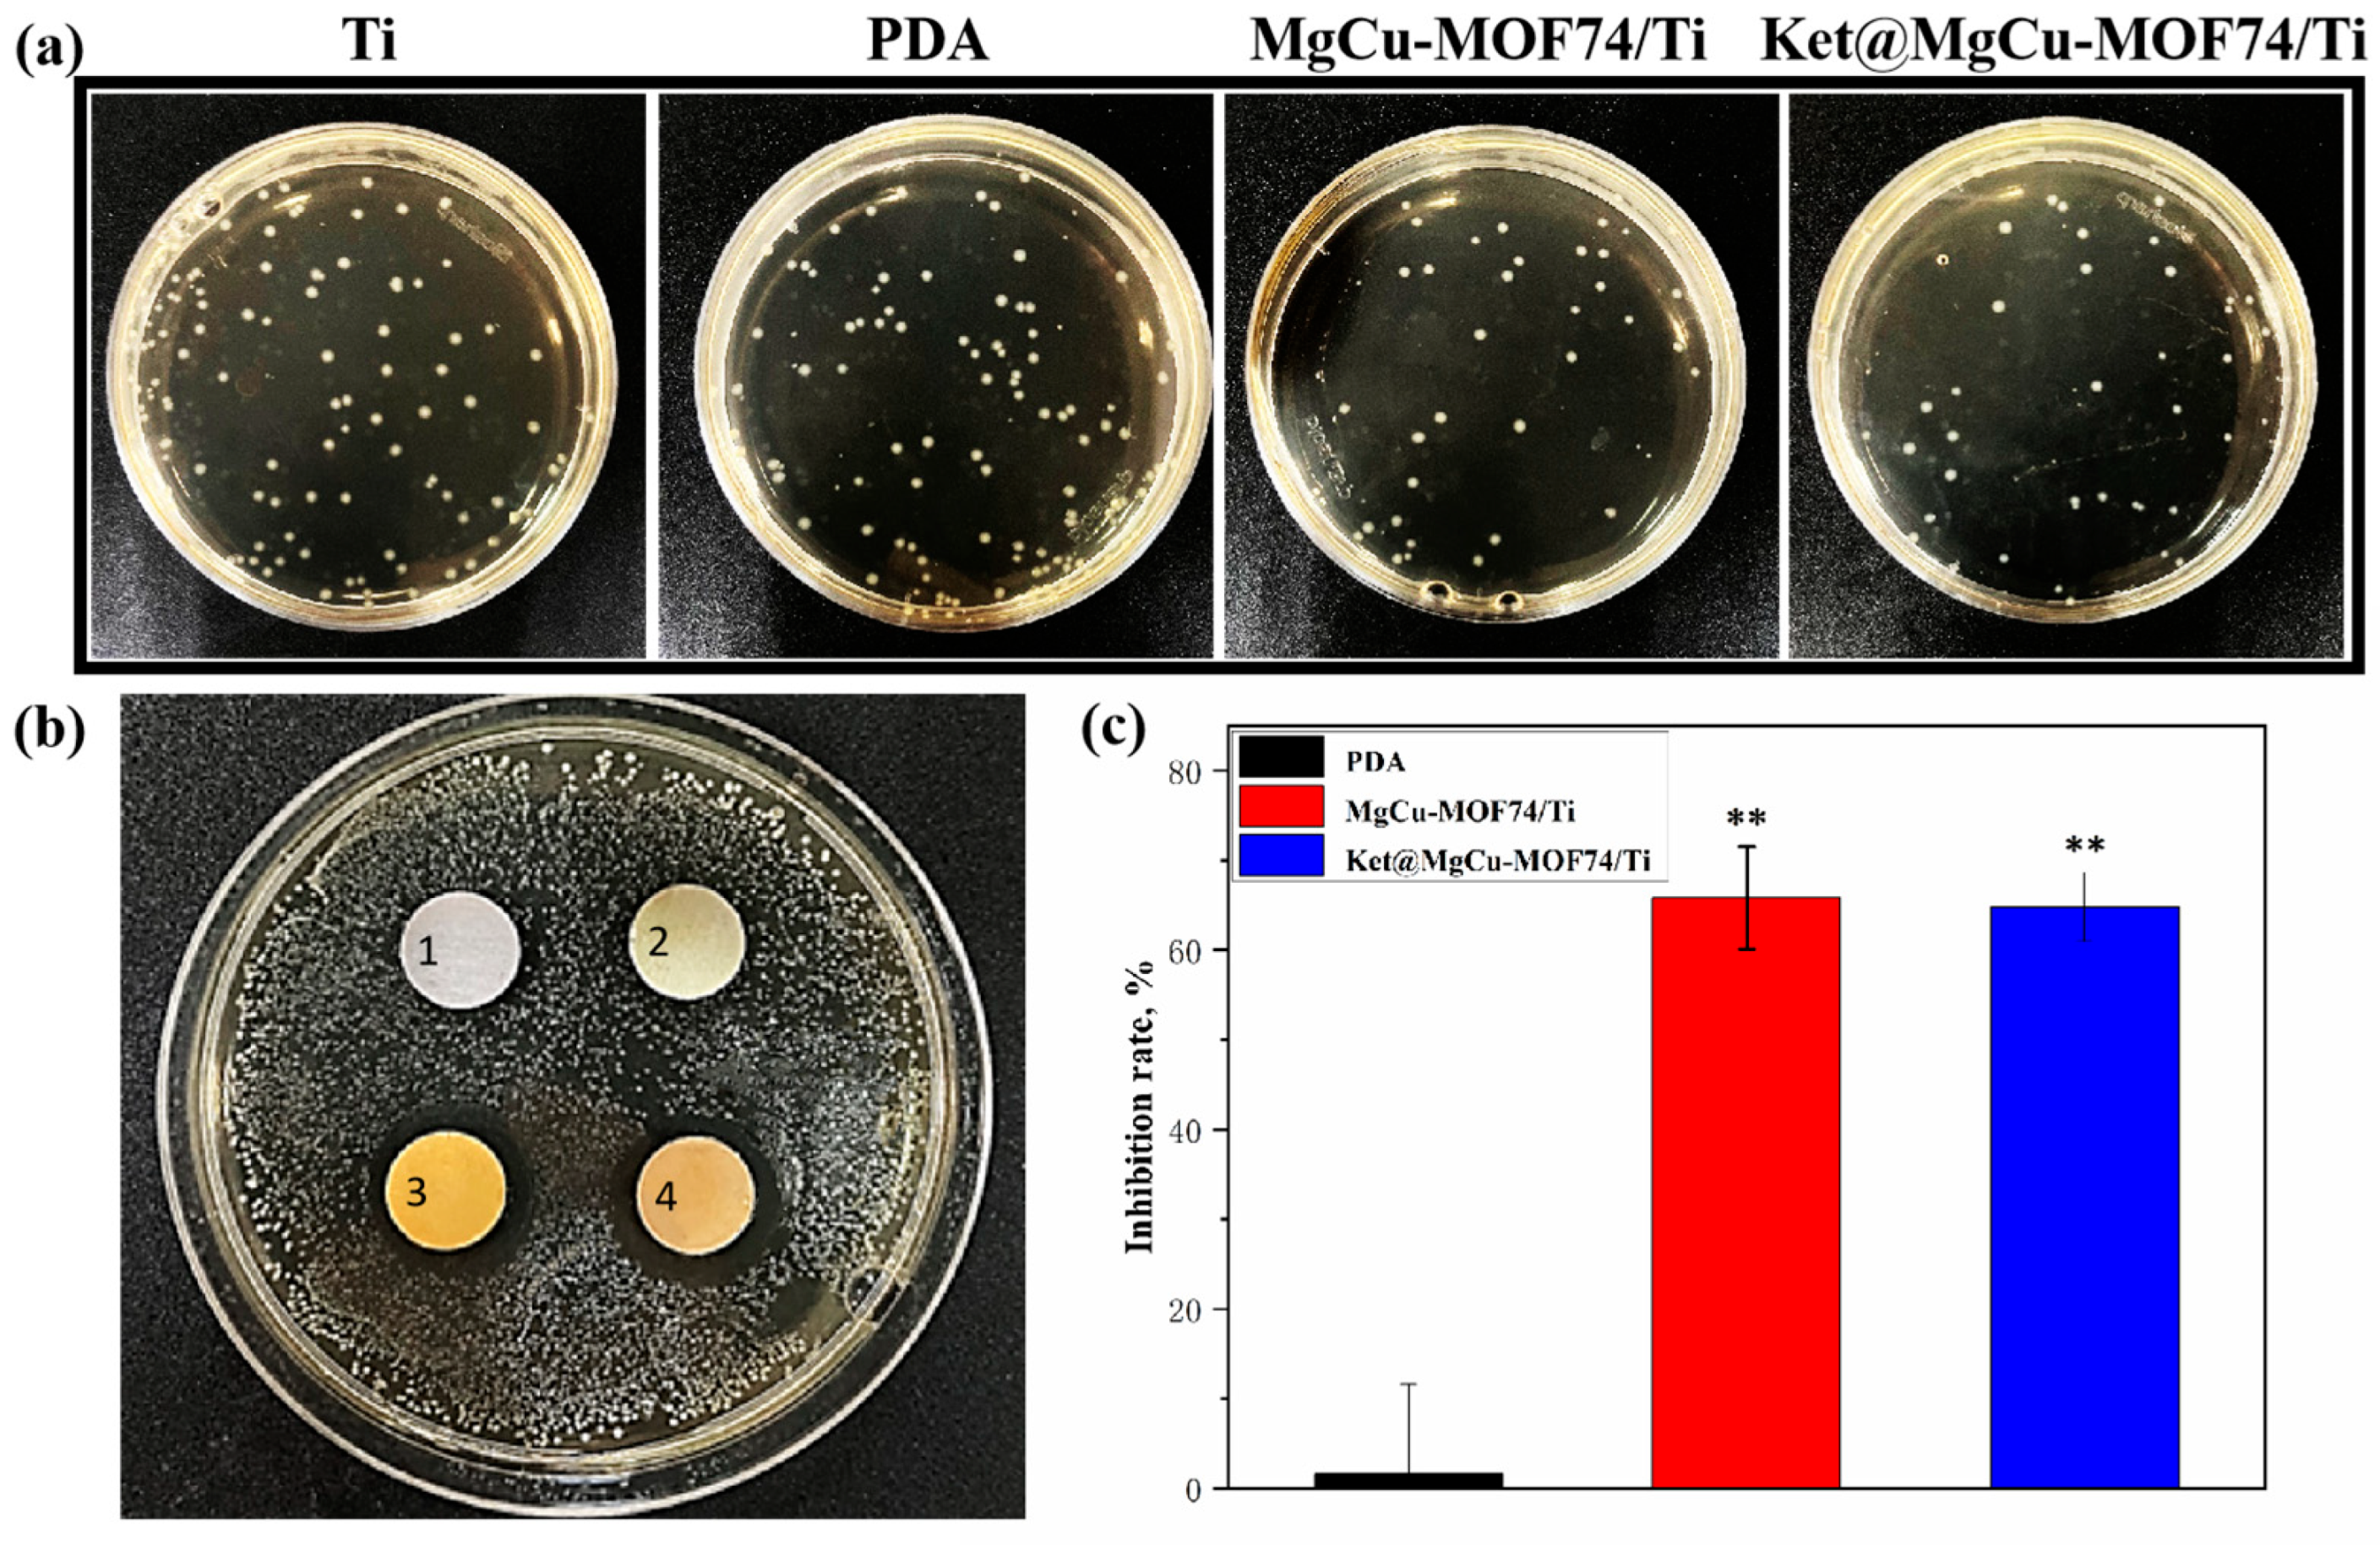
Jfb 16 00222 g010 Jfb 16 00222 g010

Enhanced Osteogenesis and Antibacterial Properties of Ketoprofen-Loaded MgCu-MOF74-Coated Titanium Alloy for Bone Implant
Abstract
1. Introduction
2. Materials and Methods
2.1. Reagents and Chemicals
2.2. Fabrication of Ket@MgCu-MOF74
2.3. Fabrication of Drug-Loaded Coating on Titanium Alloy Surface
2.4. Microstructural Characterization
2.5. Ketoprofen Loading and Release Behavior
2.6. Stability of the Coatings
2.7. Material Surface Wet Ability Test
2.8. In Vitro Experiments
2.8.1. Cell Culture
2.8.2. Cell Proliferation
2.8.3. ALP Activity
2.8.4. COL Secretion
2.8.5. Mineralization
2.9. Antibacterial Activity
2.10. Statistical Analysis
3. Results and Discussion
3.1. Characterization of Ket@MgCu-MOF74
3.2. Physical and Chemical Properties of the Coating
3.2.1. Morphology, Phase, and Chemical Composition
3.2.2. Stability of the Coatings
3.3. Biological Properties of the Coating Samples
3.3.1. Cell Biocompatibility
3.3.2. Cell Differentiation
3.4. Antibacterial Capacity
4. Conclusions
Supplementary Materials
Author Contributions
Funding
Institutional Review Board Statement
Informed Consent Statement
Data Availability Statement
Acknowledgments
Conflicts of Interest
References
- Agbedor, S.-O.; Wu, H.; Ren, Y.J.; Liang, L.X.; Yang, D.H.; Liu, B.; Liu, Y.; Baker, I. A two-decade odyssey in fusion-based additive manufacturing of titanium alloys and composites. Appl. Mater. Today 2024, 39, 102242. [Google Scholar] [CrossRef]
- Cai, L.Y.; Ren, Y.J.; Liu, X.Y.; Song, M.; Baker, I.; Wu, H. Achieving uniform hardness in additively manufactured TA15 alloy via Ni or Cu additions. Mater. Res. Lett. 2025, 13, 9–16. [Google Scholar] [CrossRef]
- Abd-Elaziem, W.; Darwish, M.A.; Hamada, A.; Daoush, W.M. Titanium-based alloys and composites for orthopedic implants Applications: A comprehensive review. Mater. Des. 2024, 241, 112850. [Google Scholar] [CrossRef]
- Liang, L.X.; Song, D.Y.; Wu, K.; Ouyang, Z.X.; Huang, Q.L.; Lei, G.H.; Zhou, K.; Xiao, J.; Wu, H. Sequential activation of M1 and M2 phenotypes in macrophages by Mg degradation from Ti-Mg alloy for enhanced osteogenesis. Biomater. Res. 2022, 26, 17. [Google Scholar] [CrossRef] [PubMed]
- Ren, Y.J.; Li, Z.C.; Wang, Q.G.; Liu, J.B.; Zhang, L.J.; Song, M.; Liu, S.F.; Guo, S.; Jiao, Z.B.; Baker, I.; et al. Effect of Nb content on microstructural evolution, mechanical and tribological properties of in situ alloyed copper-modified titanium produced using laser powder bed fusion. J. Mater. Sci. Technol. 2025, 219, 257–270. [Google Scholar] [CrossRef]
- Guo, A.X.Y.; Cheng, L.; Zhan, S.; Zhang, S.; Xiong, W.; Wang, Z.; Wang, G.; Cao, S.C. Biomedical applications of the powder-based 3D printed titanium alloys: A review. J. Mater. Sci. Technol. 2022, 125, 252–264. [Google Scholar] [CrossRef]
- Xu, N.; Fu, J.; Zhao, L.; Chu, P.K.; Huo, K. Biofunctional elements incorporated nano/microstructured coatings on titanium implants with enhanced osteogenic and antibacterial performance. Adv. Healthc. Mater. 2020, 9, 2000681. [Google Scholar] [CrossRef]
- Nikoomanzari, E.; Karbasi, M.; Melo, W.C.M.A.; Moris, H.; Babaei, K.; Giannakis, S.; Fattah-alhosseini, A. Impressive strides in antibacterial performance amelioration of Ti-based implants via plasma electrolytic oxidation (PEO): A review of the recent advancements. Chem. Eng. J. 2022, 441, 136003. [Google Scholar] [CrossRef]
- Zhang, E.; Zhao, X.; Hu, J.; Wang, R.; Fu, S.; Qin, G. Antibacterial metals and alloys for potential biomedical implants. Bioact. Mater. 2021, 6, 2569–2612. [Google Scholar] [CrossRef]
- Nowinska, D.; Osak, P.; Maszybrocka, J.; Losiewicz, B. Anodic production and characterization of biomimetic oxide layers on grade 4 titanium for medical applications. J. Funct. Biomater. 2024, 15, 180. [Google Scholar] [CrossRef]
- Teixeira, J.F.L.; de Souza, J.A.C.; Magalhaes, F.A.C.; de Oliveira, G.; de Santis, J.B.; Costa, C.A.D.; de Souza, P.P.C. Laser-modified Ti surface improves paracrine osteogenesis by modulating the expression of DKK1 in osteoblasts. J. Funct. Biomater. 2023, 14, 224. [Google Scholar] [CrossRef]
- Wu, H.; Duan, Z.; Liang, L.; Li, G.; Wang, Q.; Liu, J.; Kanwal, A.; Wang, B.; Wen, C.; Bo, L. Engineered porous bio-ceramic coating with antibacterial and excellent biocompatibility on the surface of low modulus multi-component titanium alloy. Surf. Coat. Technol. 2025, 506, 132121. [Google Scholar] [CrossRef]
- He, Y.; Zhang, Y.; Shen, X.; Tao, B.; Liu, J.; Yuan, Z.; Cai, K. The fabrication and in vitro properties of antibacterial polydopamine-LL-37-POPC coatings on micro-arc oxidized titanium. Colloid Surf. B 2018, 170, 54–63. [Google Scholar] [CrossRef]
- Guo, Z.H.; Xie, W.S.; Lu, J.S.; Guo, X.X.; Xu, J.Z.; Xu, W.L.; Chi, Y.J.; Takuya, N.; Wu, H.; Zhao, L.Y. Tannic acid-based metal phenolic networks for bio-applications: A review. J. Mater. Chem. B. 2021, 9, 4098–4110. [Google Scholar] [CrossRef]
- Hu, T.; Xu, H.; Wang, C.; Qin, H.; An, Z. Magnesium enhances the chondrogenic differentiation of mesenchymal stem cells by inhibiting activated macrophage-induced inflammation. Sci. Rep. 2018, 8, 3406. [Google Scholar] [CrossRef]
- Yang, R.; Zheng, Y.; Zhang, Y.; Li, G.; Xu, Y.; Zhang, Y.; Xu, Y.; Zhuang, C.; Yu, P.; Deng, L.; et al. Bipolar metal flexible electrospun fibrous membrane based on metal-organic framework for gradient healing of tendon-to-bone interface regeneration. Adv. Healthc. Mater. 2022, 11, 2200072. [Google Scholar] [CrossRef]
- Glenske, K.; Donkiewicz, P.; Koewitsch, A.; Milosevic-Oljaca, N.; Rider, P.; Rofall, S.; Franke, J.; Jung, O.; Smeets, R.; Schnettler, R.; et al. Applications of metals for bone regeneration. Int. J. Mol. Sci. 2018, 19, 826. [Google Scholar] [CrossRef]
- Qi, T.; Weng, J.; Yu, F.; Zhang, W.; Li, G.; Qin, H.; Tan, Z.; Zeng, H. Insights into the role of magnesium ions in affecting osteogenic differentiation of mesenchymal stem cells. Biol. Trace Elem. Res. 2021, 199, 559–567. [Google Scholar] [CrossRef]
- Yoshizawa, S.; Brown, A.; Barchowsky, A.; Sfeir, C. Role of magnesium ions on osteogenic response in bone marrow stromal cells. Connect. Tissue Res. 2014, 55, 155–159. [Google Scholar] [CrossRef]
- Liu, C.; Yang, G.; Zhou, M.; Zhang, X.; Wu, X.; Wu, P.; Gu, X.; Jiang, X. Magnesium ammonium phosphate composite cell-laden hydrogel promotes osteogenesis and angiogenesis in Vitro. ACS Omega 2021, 6, 9449–9459. [Google Scholar] [CrossRef]
- Lin, Z.; Shen, D.; Zhou, W.; Zheng, Y.; Kong, T.; Liu, X.; Wu, S.; Chu, P.K.; Zhao, Y.; Wu, J.; et al. Regulation of extracellular bioactive cations in bone tissue microenvironment induces favorable osteoimmune conditions to accelerate in situ bone regeneration. Bioact. Mater. 2021, 6, 2315–2330. [Google Scholar] [CrossRef]
- Fonseca, J.; Gong, T. Fabrication of metal-organic framework architectures with macroscopic size: A review. Coord. Chem. Rev. 2022, 462, 214520. [Google Scholar] [CrossRef]
- Zheng, W.; Meng, Z.; Zhu, Z.; Wang, X.; Xu, X.; Zhang, Y.; Luo, Y.; Liu, Y.; Pei, X. Metal-organic framework-based nanomaterials for regulation of the osteogenic microenvironment. Small 2024, 20, 2310622. [Google Scholar] [CrossRef]
- Shyngys, M.; Ren, J.; Liang, X.; Miao, J.; Blocki, A.; Beyer, S. Metal-organic framework (MOF)-based biomaterials for tissue engineering and regenerative medicine. Front. Bioeng. Biotechnol. 2021, 9, 603608. [Google Scholar] [CrossRef]
- Zhang, X.; Peng, F.; Wang, D. MOFs and MOF-Derived materials for antibacterial application. J. Funct. Biomater. 2022, 13, 215. [Google Scholar] [CrossRef]
- Wang, Q.; Liao, C.; Liu, B.; Jing, S.; Guo, Z.; Liang, L.; Liu, J.; Li, N.; Zhou, R.; Baker, I.; et al. Enhanced corrosion resistance, antibacterial properties and osteogenesis by Cu ion optimized MgAl-layered double hydroxide on Mg alloy. J. Magnes. Alloys. 2024, 12, 4174–4190. [Google Scholar] [CrossRef]
- Wang, X.; Qin, T.; Bao, S.-S.; Zhang, Y.-C.; Shen, X.; Zheng, L.-M.; Zhu, D. Facile synthesis of a water stable 3D Eu-MOF showing high proton conductivity and its application as a sensitive luminescent sensor for Cu2+ ions. J. Mater. Chem. A 2016, 4, 16484–16489. [Google Scholar] [CrossRef]
- Zhu, S.; Luo, T.; Zhang, T.; Li, Y.; Yang, Y. Effects of Cu addition on the microstructure and mechanical properties of as-cast and heat treated Mg-6Zn-4Al magnesium alloy. Mater. Sci. Eng. A-Struct. 2017, 689, 203–211. [Google Scholar] [CrossRef]
- Huang, Q.; Li, X.; Elkhooly, T.A.; Liu, X.; Zhang, R.; Wu, H.; Feng, Q.; Liu, Y. The Cu-containing TiO2 coatings with modulatory effects on macrophage polarization and bactericidal capacity prepared by micro-arc oxidation on titanium substrates. Colloid Surf. B 2018, 170, 242–250. [Google Scholar] [CrossRef]
- Wu, H.; Yang, S.; Xiao, J.; Ouyang, Z.; Yang, M.; Zhang, M.; Zhao, D.; Huang, Q. Facile synthesis of multi-functional nano-composites by precise loading of Cu2+ onto MgO nano-particles for enhanced osteoblast differentiation, inhibited osteoclast formation and effective bacterial killing. Mater. Sci. Eng. C-Mater. 2021, 130, 112442. [Google Scholar] [CrossRef]
- Huang, Q.; Ouyang, Z.; Tan, Y.; Wu, H.; Liu, Y. Activating macrophages for enhanced osteogenic and bactericidal performance by Cu ion release from micro/nano-topographical coating on a titanium substrate. Acta Biomater. 2019, 100, 415–426. [Google Scholar] [CrossRef]
- Tran Van, P.; Kang, S.G.; Chung, J.S.; Hur, S.H. Highly selective metal-organic framework-based electrocatalyst for the electrochemical reduction of CO2 to CO. Mater. Res. Bull. 2021, 138, 111228. [Google Scholar]
- Hong, J.; Li, W.; Shang, J.; Yamashita, H.; Hu, Y. Constructing Cu0/Cu+ interfaces on Cu-based MOF derivatives to promote the adsorption stability of intermediates in the process of CO2 electroreduction to C2 products. Environ. Sci. Nano 2024, 11, 4230–4239. [Google Scholar] [CrossRef]
- Liu, J.; Tan, Y.; Shen, E.; Liu, B.; Tian, Y.; Liang, L.; Yan, X.; Wu, H. Highly water-stable bimetallic organic framework MgCu-MOF74 for inhibiting bacterial infection and promoting bone regeneration. Biomed. Mater. 2022, 17, 065026. [Google Scholar] [CrossRef]
- Si, Y.; Liu, H.; Yu, H.; Jiang, X.; Sun, D. MOF-derived CuO@ZnO modified titanium implant for synergistic antibacterial ability, osteogenesis and angiogenesis. Colloids Surf. B 2022, 219, 112840. [Google Scholar] [CrossRef]
- Wang, B.; Lan, J.; Qiao, H.; Xie, L.; Yang, H.; Lin, H.; Li, X.; Huang, Y. Porous surface with fusion peptides embedded in strontium titanate nanotubes elevates osteogenic and antibacterial activity of additively manufactured titanium alloy. Colloids Surf. B. 2023, 224, 113188. [Google Scholar] [CrossRef]
- Wang, X.; Lei, X.; Yu, Y.; Miao, S.; Tang, J.; Fu, Y.; Ye, K.; Shen, Y.; Shi, J.; Wu, H.; et al. Biological sealing and integration of a fibrinogen-modified titanium alloy with soft and hard tissues in a rat model. Biomater. Sci. 2021, 9, 5192–5208. [Google Scholar] [CrossRef]
- Zhu, Y.; Liu, D.; Wang, X.; He, Y.; Luan, W.; Qi, F.; Ding, J. Polydopamine-mediated covalent functionalization of collagen on a titanium alloy to promote biocompatibility with soft tissues. J. Mater. Chem. B 2019, 7, 2019–2031. [Google Scholar] [CrossRef]
- Harder, A.T.; An, Y.H. The mechanisms of the inhibitory effects of nonsteroidal anti-inflammatory drugs on bone healing: A concise review. J. Clin. Pharmacol. 2003, 43, 807–815. [Google Scholar] [CrossRef]
- Lisowska, B.; Kosson, D.; Domaracka, K. Positives and negatives of nonsteroidal anti-inflammatory drugs in bone healing: The effects of these drugs on bone repair. Drug. Des. Devel. Ther. 2018, 12, 1809–1814. [Google Scholar] [CrossRef]
- Zhang, Y.; Cheng, Z.; Liu, Z.; Shen, X.; Cai, C.; Li, M.; Luo, Z. Functionally tailored metal—Organic framework coatings for mediating Ti implant osseointegration. Adv. Sci. 2023, 10, 2303958. [Google Scholar] [CrossRef]
- Si, Y.; Liu, H.; Li, M.; Jiang, X.; Yu, H.; Sun, D. An efficient metal–organic framework-based drug delivery platform for synergistic antibacterial activity and osteogenesis. J. Colloid Interface Sci. 2023, 640, 521–539. [Google Scholar] [CrossRef]
- Lawson, H.D.; Walton, S.P.; Chan, C. Metal–organic frameworks for drug delivery: A design perspective. ACS Appl. Mater. Interfaces 2021, 13, 7004–7020. [Google Scholar] [CrossRef]
- Dantas, F.L.; Rodriguez Llanos, J.H.; Pereira Rodrigues, I.C.; Pereira, K.D.; Luchessi, A.D.; Sawazaki, R.; Lopes, É.S.N.; Gabriel, L.P. PLLA scaffolds functionalized with ketoprofen via rotary jet spinning for biomedical applications. J. Mater. Res. Technol. 2024, 30, 9020–9027. [Google Scholar] [CrossRef]
- Wu, C.; Chu, X.; Wu, X.; Zhou, H.; Zeng, Y.; Wang, D.; Liu, W. Size and morphology control over MOF-74 crystals. RSC Adv. 2024, 14, 20604–20608. [Google Scholar] [CrossRef]
- Bao, Z.B.; Yu, L.A.; Ren, Q.L.; Lu, X.Y.; Deng, S.G. Adsorption of CO2 and CH4 on a magnesium-based metal organic framework. J. Colloid Interface Sci. 2011, 353, 549–556. [Google Scholar] [CrossRef]
- Xie, S.Z.; Qin, Q.J.; Liu, H.; Jin, L.J.; Wei, X.L.; Liu, J.X.; Liu, X.; Yao, Y.C.; Dong, L.H.; Li, B. MOF-74-M (M = Mn, Co, Ni, Zn, MnCo, MnNi, and MnZn) for low-temperature NH3-SCR and in Situ DRIFTS study reaction mechanism. ACS Appl. Mater. Interfaces 2020, 12, 48476–48485. [Google Scholar] [CrossRef]
- Hu, J.Q.; Chen, Y.; Zhang, H.; Chen, Z.X. Controlled syntheses of Mg-MOF-74 nanorods for drug delivery. J. Solid State Chem. 2021, 294, 121853. [Google Scholar] [CrossRef]
- Li, Z.; Peng, Y.; Xia, X.Y.; Cao, Z.; Deng, Y.Q.; Tang, B. Sr/PTA Metal organic framework as a drug delivery system for osteoarthritis treatment. Sci. Rep. 2019, 9, 17570. [Google Scholar] [CrossRef]
- Abid, H.R.; Azhar, M.R.; Iglauer, S.; Rada, Z.H.; Al-Yaseri, A.; Keshavarz, A. Physicochemical characterization of metal organic framework materials: A mini review. Heliyon 2024, 10, e23840. [Google Scholar] [CrossRef]
- Romero-Muñiz, C.; Gavira-Vallejo, J.M.; Merkling, P.J.; Calero, S. Impact of small adsorbates in the vibrational spectra of Mg- and Zn-MOF-74 revealed by first-principles calculations. ACS Appl. Mater. Interfaces 2020, 12, 54980–54990. [Google Scholar] [CrossRef]
- Schnabel, J.; Ettlinger, R.; Bunzen, H. Zn-MOF-74 as pH-responsive drug-delivery system of arsenic trioxide. Chem. Nano Mat. 2020, 6, 1229–1236. [Google Scholar] [CrossRef]
- Yadav, P.S.; Kumar, V.; Singh, U.P.; Bhat, H.R.; Mazumder, B. Physicochemical characterization and in vitro dissolution studies of solid dispersions of ketoprofen with PVP K30 and D-mannitol. Saudi Pharm. J. 2013, 21, 77–84. [Google Scholar] [CrossRef]
- Wang, H.; Cheng, L.; Wen, H.; Li, C.; Li, Y.; Zhang, X.; Wang, Y.; Wang, Y.; Wang, T.; Pan, W.; et al. A time-adjustable pulsatile release system for ketoprofen: In vitro and in vivo investigation in a pharmacokinetic study and an IVIVC evaluation. Eur. J. Pharm. Biopharm. 2017, 119, 192–200. [Google Scholar] [CrossRef]
- Li, Z.; Zhao, S.J.; Wang, H.Z.; Peng, Y.; Tan, Z.J.; Tang, B. Functional groups influence and mechanism research of UiO-66-type metal-organic frameworks for ketoprofen delivery. Colloids Surf. B. 2019, 178, 1–7. [Google Scholar] [CrossRef]
- Ouyang, L.; Qi, M.Y.; Wang, S.N.; Tu, S.; Li, B.G.; Deng, Y.; Yang, W.Z. Osteogenesis and antibacterial activity of graphene oxide and dexamethasone coatings on porous polyetheretherketone via polydopamine-assisted chemistry. Coatings 2018, 8, 203. [Google Scholar] [CrossRef]
- Xu, D.; Qian, J.; Guan, X.; Ren, L.; Yang, K.; Huang, X.; Zhang, S.; Chai, Y.; Wu, X.; Wu, H.; et al. Copper-containing alloy as immunoregulatory material in bone regeneration via mitochondrial oxidative stress. Front. Bioeng. Biotechnol. 2021, 8, 620629. [Google Scholar] [CrossRef]
- Geetha, M.; Singh, A.K.; Asokamani, R.; Gogia, A.K. Ti based biomaterials, the ultimate choice for orthopaedic implants—A review. Prog. Mater. Sci. 2009, 54, 397–425. [Google Scholar] [CrossRef]
- Wang, J.; Zhang, S.; Sun, Z.; Wang, H.; Ren, L.; Yang, K. Optimization of mechanical property, antibacterial property and corrosion resistance of Ti-Cu alloy for dental implant. J. Mater. Sci. Technol. 2019, 35, 2336–2344. [Google Scholar] [CrossRef]
- Li, A.; Wang, Q.; Chen, R.; Ding, X.; Su, Y.; Fu, H. Application of alloying for enhancing the corrosion resistance of titanium alloys: A review. Mater. Today Commun. 2025, 42, 111111. [Google Scholar] [CrossRef]
- Chen, X.; Li, W.; Wang, N.; Qi, M.; Liu, L.; Zhao, Z. Enhanced corrosion resistance of Ti65 alloys through chromium magnetron sputtering and laser remelting: A synergistic surface engineering strategy. J. Mater. Res. Technol. 2025, 36, 6767–6777. [Google Scholar] [CrossRef]
- Gai, K.; Zhang, T.; Xu, Z.; Li, G.; He, Z.; Meng, S.; Shi, Y.; Zhang, Y.; Zhu, Z.; Pei, X.; et al. Biomimetic management of bone healing stages: MOFs induce tunable degradability and enhanced angiogenesis-osteogenesis coupling. Chem. Eng. J. 2024, 493, 152296. [Google Scholar] [CrossRef]
- Shen, X.; Zhang, Y.; Ma, P.; Sutrisno, L.; Luo, Z.; Hu, Y.; Yu, Y.; Tao, B.; Li, C.; Cai, K. Fabrication of magnesium/zinc-metal organic framework on titanium implants to inhibit bacterial infection and promote bone regeneration. Biomaterials 2019, 212, 1–16. [Google Scholar] [CrossRef]
- Chen, M.; Wang, D.; Li, M.; He, Y.; He, T.; Chen, M.; Hu, Y.; Luo, Z.; Cai, K. Nanocatalytic biofunctional MOF coating on Titanium implants promotes osteoporotic bone regeneration through cooperative proosteoblastogenesis MSC reprogramming. ACS Nano 2022, 16, 15397–15412. [Google Scholar] [CrossRef]
- Zhu, Z.; Jiang, S.; Liu, Y.; Gao, X.; Hu, S.; Zhang, X.; Huang, C.; Wan, Q.; Wang, J.; Pei, X. Micro or nano: Evaluation of biosafety and biopotency of magnesium metal organic framework-74 with different particle sizes. Nano Res. 2020, 13, 511–526. [Google Scholar] [CrossRef]
- Liu, R.; Tang, Y.; Liu, H.; Zeng, L.; Ma, Z.; Li, J.; Zhao, Y.; Ren, L.; Yang, K. Effects of combined chemical design (Cu addition) and topographical modification (SLA) of Ti-Cu/SLA for promoting osteogenic, angiogenic and antibacterial activities. J. Mater. Sci. Technol. 2020, 47, 202–215. [Google Scholar] [CrossRef]
- Li, F.; Li, S.; Liu, Y.; Zhang, Z.; Li, Z. Current advances in the roles of doped bioactive metal in biodegradable polymer composite scaffolds for bone repair: A mini review. Adv. Eng. Mater. 2022, 24, 2101510. [Google Scholar] [CrossRef]
- Ge, Y.; Wang, K.; Li, H.; Tian, Y.; Wu, Y.; Lin, Z.; Lin, Y.; Wang, Y.; Zhang, J.; Tang, B. An Mg-MOFs based multifunctional medicine for the treatment of osteoporotic pain. Mater. Sci. Eng. C-Mater. 2021, 129, 112386. [Google Scholar] [CrossRef]
- Jian, Y.; Zou, J.; Zheng, J.; Liao, D.; Lan, Q.; Prakash, O.; Liu, J.; Kumar, A.; Ouyang, J.; Pan, Y. Current status and prospect of MOF-74-based materials for biomedical applications. J. Drug Deliv. Sci. Technol. 2024, 94, 105470. [Google Scholar] [CrossRef]
- Huang, Q.L.; Li, X.Z.; Liu, T.; Wu, H.; Liu, X.J.; Feng, Q.L.; Liu, Y. Enhanced SaOS-2 cell adhesion, proliferation and differentiation on Mg-incorporated micro/nano-topographical TiO2 coatings. Appl. Surf. Sci. 2018, 447, 767–776. [Google Scholar] [CrossRef]
- Wibberley, A.; McCafferty, G.P.; Evans, C.; Edwards, R.M.; Hieble, J.P. Dual, but not selective, COX-1 and COX-2 inhibitors, attenuate acetic acid-evoked bladder irritation in the anaesthetised female cat. Br. J. Pharmacol. 2006, 148, 154–161. [Google Scholar] [CrossRef][Green Version]
- van der Heide, H.J.L.; Hannink, G.; Buma, P.; Schreurs, B.W. No effect of ketoprofen and meloxicam on bone graft ingrowth—A bone chamber study in goats. Acta Orthop. 2008, 79, 548–554. [Google Scholar] [CrossRef] [PubMed]
- An, Y.; Zhang, H.; Zhang, S.; Zhang, Y.; Zheng, L.; Chen, X.; Tong, W.; Xu, J.; Qin, L. Degradation products of magnesium implant synergistically enhance bone regeneration: Unraveling the roles of hydrogen gas and alkaline environment. Bioact. Mater. 2025, 46, 331–346. [Google Scholar] [CrossRef]
- Chatterjee, A.K.; Chakraborty, R.; Basu, T. Mechanism of antibacterial activity of copper nanoparticles. Nanotechnology 2014, 25, 135101. [Google Scholar] [CrossRef] [PubMed]
- Li, J.Y.; Zhai, D.; Lv, F.; Yu, Q.Q.; Ma, H.S.; Yin, J.B.; Yi, Z.F.; Liu, M.Y.; Chang, J.; Wu, C.T. Preparation of copper-containing bioactive glass/eggshell membrane nanocomposites for improving angiogenesis, antibacterial activity and wound healing. Acta Biomater. 2016, 36, 254–266. [Google Scholar] [CrossRef] [PubMed]
- Castrillón, S.R.V.; Perreault, F.; de Faria, A.F.; Elimelech, M. Interaction of graphene oxide with bacterial cell membranes: Insights from force spectroscopy. Environ. Sci. Technol. Lett. 2015, 2, 112–117. [Google Scholar] [CrossRef]
- Foster, J.W. Escherichia coli acid resistance: Tales of an amateur acidophile. Nat. Rev. Microbiol. 2004, 2, 898–907. [Google Scholar] [CrossRef]
- Bae, Y.-M.; Lee, S.-Y. Effect of salt addition on acid resistance response of Escherichia coli O157:H7 against acetic acid. Food Microbiol. 2017, 65, 74–82. [Google Scholar] [CrossRef]
- Feng, H.Q.; Wang, G.M.; Jin, W.H.; Zhang, X.M.; Huang, Y.F.; Gao, A.; Wu, H.; Wu, G.S.; Chu, P.K. Systematic study of inherent antibacterial properties of Magnesium-based biomaterials. ACS Appl. Mater. Interfaces 2016, 8, 9662–9673. [Google Scholar] [CrossRef]
- Ho, C.-C.; Ding, S.-J. Novel SiO2/PDA hybrid coatings to promote osteoblast-like cell expression on titanium implants. J. Mater. Chem. B 2015, 3, 2698–2707. [Google Scholar] [CrossRef]

Disclaimer/Publisher’s Note: The statements, opinions and data contained in all publications are solely those of the individual author(s) and contributor(s) and not of MDPI and/or the editor(s). MDPI and/or the editor(s) disclaim responsibility for any injury to people or property resulting from any ideas, methods, instructions or products referred to in the content. |
© 2025 by the authors. Licensee MDPI, Basel, Switzerland. This article is an open access article distributed under the terms and conditions of the Creative Commons Attribution (CC BY) license (https://creativecommons.org/licenses/by/4.0/).
Share and Cite
Duan, Z.; Yao, Y.; Liu, J.; Tan, Y.; Wang, Q.; Fang, M.; Kanwal, A.; Cheng, S.; Huang, J.; Wu, H. Enhanced Osteogenesis and Antibacterial Properties of Ketoprofen-Loaded MgCu-MOF74-Coated Titanium Alloy for Bone Implant. J. Funct. Biomater. 2025, 16, 222. https://doi.org/10.3390/jfb16060222
Duan Z, Yao Y, Liu J, Tan Y, Wang Q, Fang M, Kanwal A, Cheng S, Huang J, Wu H. Enhanced Osteogenesis and Antibacterial Properties of Ketoprofen-Loaded MgCu-MOF74-Coated Titanium Alloy for Bone Implant. Journal of Functional Biomaterials. 2025; 16(6):222. https://doi.org/10.3390/jfb16060222
Chicago/Turabian StyleDuan, Ziqing, Yifeng Yao, Jiamin Liu, Yanni Tan, Qingge Wang, Man Fang, Aqsa Kanwal, Shuqiao Cheng, Juan Huang, and Hong Wu. 2025. "Enhanced Osteogenesis and Antibacterial Properties of Ketoprofen-Loaded MgCu-MOF74-Coated Titanium Alloy for Bone Implant" Journal of Functional Biomaterials 16, no. 6: 222. https://doi.org/10.3390/jfb16060222
APA StyleDuan, Z., Yao, Y., Liu, J., Tan, Y., Wang, Q., Fang, M., Kanwal, A., Cheng, S., Huang, J., & Wu, H. (2025). Enhanced Osteogenesis and Antibacterial Properties of Ketoprofen-Loaded MgCu-MOF74-Coated Titanium Alloy for Bone Implant. Journal of Functional Biomaterials, 16(6), 222. https://doi.org/10.3390/jfb16060222

